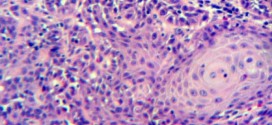

El hipernefroma maligno. Tumor maligno en general y especialmente el formado por células epiteliales, se presenta en el parénquima del riñón, es la forma más usual de cáncer y se origina en la proliferación de células epiteliales de los túbulos renales. Durante los primeros años de vida de una persona, las células normales se dividen más rápidamente para permitir el …
Leer MásEnfermedades
DERMOGRAFISMO
La dermografismo. Estado o reacción anormal de la piel ante un estímulo mecánico como la presión ejercida con una uña o estilete; la zona estimulada reacciona como si se tratase de una urticaria (autografismo): primero se enrojece y posteriormente se vuelve blancorosa y sobresaliente, dejando marcas elevadas. Parece estar relacionado con disfunciones vasomotoras. El dermografismo consiste en una tendencia exagerada …
Leer MásCARCINOMAS DEL TRACTO URINARIO
El carcinoma del tracto urinario. Tumor maligno en general y especialmente el formado por células epiteliales, se presenta en el parénquima del riñón, es la forma más usual de cáncer y se origina en la proliferación de células epiteliales de los túbulos renales. El tumor urotelial del aparato urinario es un proceso infrecuente responsable de menos del 5% de los …
Leer MásCARCINOMAS INTRAEPITELIALES
Los carcinomas intraepiteliales. Es desconocida, pero podría ser por acción de un virus (Herpes virus II). A saber. Tiene una mayor frecuencia en africanas e hindúes, es raro es israelitas por la circuncisión masculina, la cual da una mayor higiene del miembro y desaparición del esmegma. Es muy raro que se presente en vírgenes y en monjas. Aumenta su frecuencia en …
Leer MásCARCINOSARCOMA PROSTÁTICO
El carcinosarcoma prostático. Tumor maligno en general y especialmente el formado por células epiteliales. El carcinosarcoma de próstata es un tumor agresivo, poco frecuente, compuesto por dos elementos, uno epitelial y otro mesenquimatoso. Existen alrededor de cuarenta casos bien documentados en la literatura de los que en su mayoría se presentan en forma sincrónica. La histogénesis de este tumor es …
Leer MásCARCINOMAS UROTELIALES
Los carcinomas uroteliales. Tumor maligno en general y especialmente el formado por células epiteliales, se presenta en el parénquima del riñón, es la forma más usual de cáncer y se origina en la proliferación de células epiteliales de los túbulos renales. Los carcinomas uroteliales son los cuartos tumores más frecuentes después de los de próstata (o mama), pulmón y colorrectal. …
Leer MásCARCINOMA SUBGLOTIS
El carcinoma subglotis. Si la afectación subglótico es por invasión de un tumor extra laríngeo, por ejemplo tiroideo, el primer síntoma será la parálisis de cuerda vocal uní ó bilateral por compresión ó infiltración tumoral de uno ó los dos recurrentes. También podemos encontrar una deformidad traqueal, que puede ser la causa de la disnea. De aquí la importancia que …
Leer MásANGIOFIBROMA NASOFARINGEO JUVENIL
El angiofibroma nasofaríngeo juvenil. Otras denominaciones: Fibroma sangrante de la pubertad masculina, Fibroma juvenil, Fibroide basal, Angiofibroma telangiectásico, Fibroangioma, Tumor del glomus nasofaríngeo. El Angiofibroma Nasofaríngeo Juvenil fue descrito por Chelius en 1897 como un pólipo nasal fibroso que se presenta durante la pubertad. El angiofibroma juvenil nasofaríngeo es una rara enfermedad que se diagnostica típicamente en la adolescencia en …
Leer MásCATATONÍA
La catatonía. Síndrome caracterizado por Trastorno psicomotor cuyos síntomas son la conservación de la actitud que se le da a un miembro, la inercia, el negativismo hacia el medio externo, periodos de rigidez física, agitación y estupor, la repetición continua de los mismos gestos, accesos de agitación motora, incluso con comportamientos violentos. Estado característico de algunas enfermedades psiquiátricas que se …
Leer MásCATALEPSIA
La catalepsia. Estado caracterizado por la pérdida de la contractilidad voluntaria de los músculos y de la sensibilidad. La catalepsia no es una enfermedad propiamente dicha, sino que constituye un síntoma de otros trastornos como el Parkinson, la epilepsia, la esquizofrenia, apnea de sueño, obesidad, depresión, shock emocional, y un largo etcétera. También puede darse como efecto secundario de medicamentos …
Leer MásCARNE DE GALLINA, HORRIPILACIÓN
La carne de gallina o horripilación. Carne de gallina, horripilación o cutis anserina, esta provocado por erección de las papilas dérmicas por acción del frío o de las emociones, etc. Pues bien una vez diagnosticado cual es la enfermedad o nombre de dicha patología, lo primero que debería de hacer es él no abusar en cremas o pomadas externas. De …
Leer MásCARCINOMA VESICULAR
El carcinoma vesicular. Es una enfermedad por la cual se forman células malignas cancerosas en los tejidos de la vesícula biliar es una enfermedad poco frecuente por la que se encuentran células cancerosas en los tejidos de la vesícula biliar. Tumor maligno en general y especialmente el formado por células epiteliales, a saber. Durante los primeros años de vida de …
Leer MásCARCINOMA TUBULAR DE MAMA
El carcinoma tubular de mama. Durante los primeros años de vida de una persona, las células normales se dividen más rápidamente para permitir el crecimiento. El cuerpo está compuesto por billones de células vivas. Las células normales del cuerpo crecen, se dividen formando nuevas células y mueren de manera ordenada. Una vez que se llega a la edad adulta, la …
Leer MásCARCINOMA RENAL DEL TÚBULO COLECTOR
El carcinoma renal del túbulo colector. También llamado: carcinoma renal, carcinoma de túbulos colectores, carcinoma túbulo-quístico, nefrona inferior, inmunohistoquímica. Los riñones son un par de órganos en forma de frijol, cada uno alrededor del tamaño del puño de la mano, y con un peso aproximado entre 130 y 140 gramos (aprox. de 4 a 5 onzas). Se ubican en la …
Leer MásCARCINOMA VESICAL
El carcinoma vesical. La vejiga es un órgano que almacena la orina a baja presión, se vacía por completo de forma voluntaria y mantiene la continencia en los intervalos. Anatómicamente está formada por dos capas diferentes: una mucosa en contacto con la orina que se denomina urotelio y un músculo llamado detrusor, situado en profundidad y responsable de la contracción …
Leer MásCARCINOMA UROTELIAL
El carcinoma urotelial. Tumor maligno en general y especialmente el formado por células epiteliales, se presenta en el parénquima del riñón, es la forma más usual de cáncer y se origina en la proliferación de células epiteliales de los túbulos renales. Durante los primeros años de vida de una persona, las células normales se dividen más rápidamente para permitir el …
Leer MásCARCINOMA RENAL DEL CONDUCTO COLECTOR
El carcinoma renal del conducto colector. Tumor maligno en general y especialmente el formado por células epiteliales, se presenta en el parénquima del riñón, es la forma más usual de cáncer y se origina en la proliferación de células epiteliales de los túbulos renales. Es más común en hombres que en las mujeres y no es común que afecte a …
Leer MásTUMOR DEL SULCUS SUPERIOR
El tumor del sulcus superior. Durante los primeros años de vida de una persona, las células normales se dividen más rápidamente para permitir el crecimiento. El cuerpo está compuesto por billones de células vivas. Las células normales del cuerpo crecen, se dividen formando nuevas células y mueren de manera ordenada. Una vez que se llega a la edad adulta, la …
Leer MásTUMOR MALIGNO DEL BAZO
El tumor maligno del bazo. Tumor maligno en general y especialmente el formado por células epiteliales, a saber. Los canceres se dividen en dos grandes categorías de carcinoma y sarcoma u otros. Órgano linfoide hematopoyético y hematolítico, de 12,5cn de longitud y 200 gramos de peso, situado profundamente en el hipocondrio (región superior y lateral del abdomen a cada lado …
Leer MásTUMOR MALIGNO DE MAMA
El tumor maligno de mama. Durante los primeros años de vida de una persona, las células normales se dividen más rápidamente para permitir el crecimiento. El cuerpo está compuesto por billones de células vivas. Las células normales del cuerpo crecen, se dividen formando nuevas células y mueren de manera ordenada. Una vez que se llega a la edad adulta, la …
Leer Más Binipatia e higienismo Medicina natural alternativa, plantas medicinales y remedios caseros naturales
Binipatia e higienismo Medicina natural alternativa, plantas medicinales y remedios caseros naturales